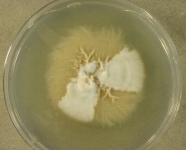

<< back to search
IMAGES:





Search Details
add to cart
| UAMH Number: | 11030 |
|---|---|
| Species Name: | Microsporum ferrugineum |
| Type: | |
| Synonyms: | Achorion ferrugineum / Arthrosporia ferruginea / Arthrosporia ferrugineum / Grubyella ferruginea / Microsporum aureum / Microsporum japonicum / Microsporum orientale / Oidium microsporium var. japonicum / Trichophyton ferrugineum |
| Taxonomy: | FUNGI Ascomycota, Eurotiomycetes, Onygenales, Arthrodermataceae |
| Strain History: | Woodgyer, A. (2008-12296) -> UAMH |
| Substrate: | tinea capitis, Karen refugee | Location: | AUSTRALIA Victoria, Melbourne (GEO: -37.814,144.963) |
| Isolator: | A. Woodgyer |
| Isolation Date: | |
| Date Received: | 2009-04-24 |
| Characters: | |
| Compounds: | |
| Cross Reference: | |
| Pathogenic Potential: | Human: yes | Animal: no | Plant: no |
| Biosafety Risk Group: | RG2 (check the PHAC ePATHogen Risk Group Database for updates) |
| Regulatory Requirements: | Canadian requesters must provide PHAC Pathogen and Toxin License Number (see: https://www.canada.ca/en/public-health/services/laboratory-biosafety-biosecurity/licensing-program.html) and a CFIA Written Authorization for transfer (http://www.inspection.gc.ca/plants/plant-pests-invasive-species/directives/date/d-12-03/eng/1432656209220/1432751554580#app2) prior to shipment. International requesters must provide all legally required importation documentation prior to shipment. Plant pathogenicity status may be verified by using the USDA Agricultural Research Service (ARS) Fungal Database |
| MycoBank ID: | 361756 |
IMAGES: